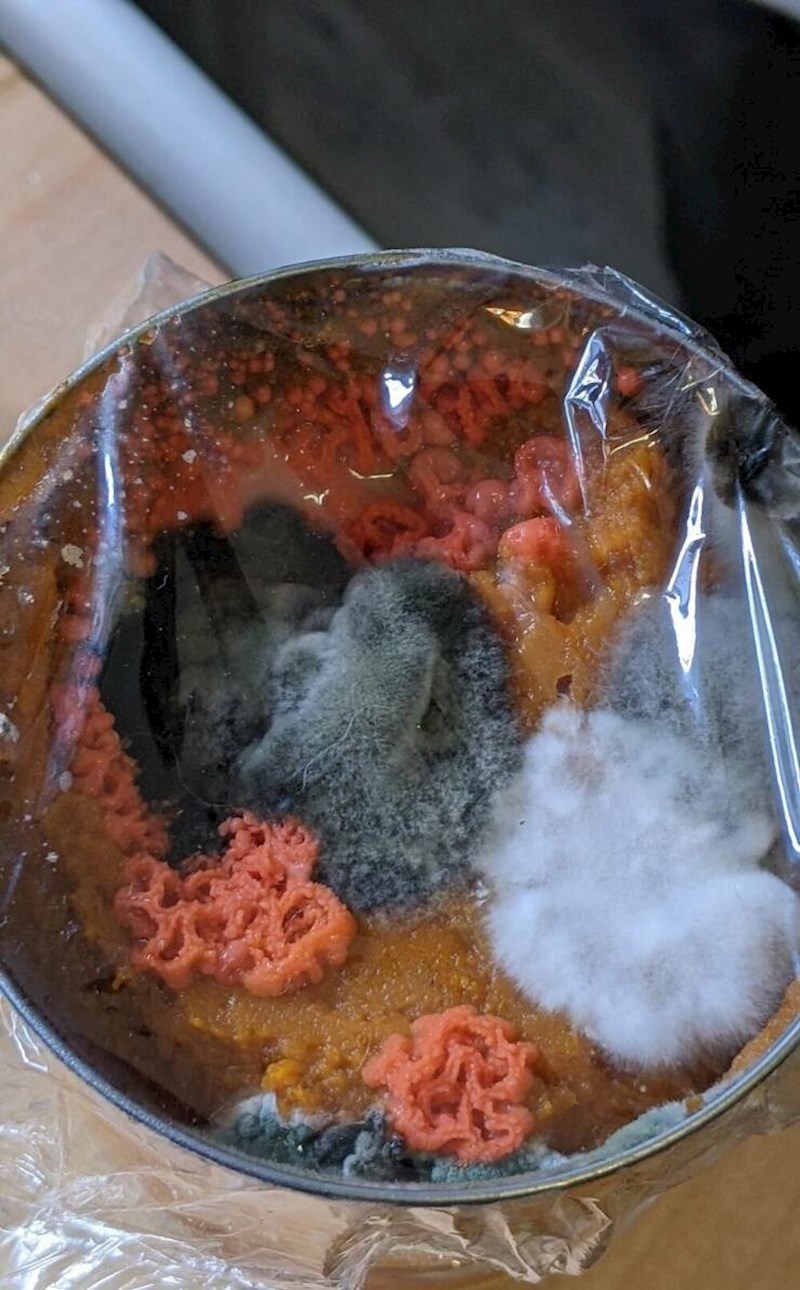
11. Pire od bundeve na koji sam zaboravila i ostavila ga u frižideru tijekom ljeta dok me nije bilo razvio je razne kulture po sebi

Razno
• 22 kolovoza 2023
19 ljudi uočili su prezanimljive prizore i morali ih odmah podijeliti sa svima na internetu

37K
Naša svakodnevica može biti itekako zanimljiva, samo trebamo pažljivo promatrati svijet oko sebe.
A kad to naučimo - sigurno ćemo, baš poput naših junaka, puno češće primjećivati zanimljive prizore oko sebe. 😁
A kad to naučimo - sigurno ćemo, baš poput naših junaka, puno češće primjećivati zanimljive prizore oko sebe. 😁
1. Netko je primijetio tipove koji su slučajno obučeni kao likovi iz crtića Alvin i vjeverice

2. Žile na ušima ove mace su baš fascinantne

3. Dobio sam cijeli krumpir u pakiranju pomfrita

4. Pauk je popravio moja vrata 😄

5. Reklama za benzinsku koja je udaljena samo otprilike 8 sati vožnje 🤣

6. U ovom restoranu umake poslužuju u kornetima od waffla

7. Tijekom šetnje šumom naišao sam na golemi plug

8. Kuća uz koju dobijete besplatne tacose u vrijednosti od 250 dolara

9. Stari silos pretvoren je u zid za penjanje

10. Zanimljivo izdanje NatGea

11. Pire od bundeve na koji sam zaboravila i ostavila ga u frižideru tijekom ljeta dok me nije bilo razvio je razne kulture po sebi
12. Izgrebana šalica ima zanimljiv uzorak

13. Vjeverica koju sam danas uočio ima nešto čudno oko vrata

14. Neobičan auto koji sam danas uočio u prometu

15.

16. Zalogajnica u SAD-u koja se nije promijenila od 90-ih

17. Buba je sletjela na mene i snijela jaja

18. Moj prijatelj i barmen iz kafića u kojem smo bili imaju istu tetovažu

19. Gooolemi wc u jednoj zračnoj luci

















